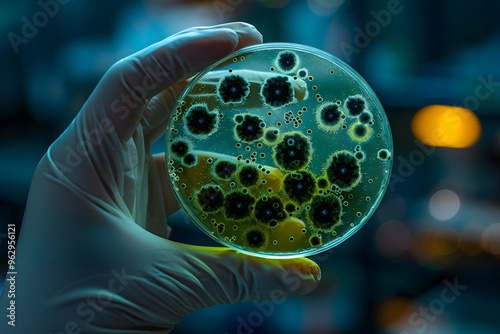

Download sample
File Details
Published: 2024-09-07 11:47:52.514340 Category: Science Type: Illustration Model release: NoShare
Close-up of Gloved Hand Holding Petri Dish with Vibrant Bacteria and Stunning Black Spots in a Laboratory Setting, Highlighting Microbial Research and Spore Growth. Generative AI
Contributor: Chirus
ID : 962956121
